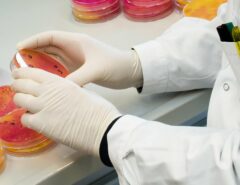
Eine Person mit Laborproben.

Hunde merken, wenn sie ungerecht behandelt werden. Das ist schon länger bekannt. Eine neue Studie der Vetmeduni Wien hat nun gezeigt, dass Hunde Gerechtigkeit auch unabhängig von ihrer Rasse schätzen.

Foto: Jozef Fehér / Pexels.
Zur Kooperation erzogen
Menschen züchten Hunde seit Ewigkeiten nach bestimmten Merkmalen. Eines dieser Merkmale ist die Fähigkeit zur Kooperation mit Menschen, wie das etwa bei Schäferhunden der Fall ist, anders als bei Schlittenhunden. Forscher*innen vom Domestication Lab des Konrad-Lorenz-Instituts für Vergleichende Verhaltensforschung und dem Messerli-Forschungsinstitut der Vetmeduni Vienna haben nun in einer Studie untersucht, ob Hunde, denen Kooperationsfähigkeit nachgesagt wird, eher einen Sinn für Gerechtigkeit haben als andere Rassen.
Man müsse hier allerdings bedenken, so der Studienleiter Jim McGetrick, dass man bei Tieren nicht generell von einem Sinn für Gerechtigkeit sprechen könne wie beim Menschen. Hunde, wie auch andere Tiere, reagieren negativ darauf, wenn sie selbst ungerecht behandelt werden – nicht aber, wenn das anderen passiert.

Foto: Mylene Quervel-Chaumette.
Wurst oder Karotte?
In der Studie wurden jeweils zwölf Hunde einer mehr und einer weniger kooperativen Rasse getestet. Sie mussten in Paaren mehrmals die Pfote geben. Im ersten Teil des Versuchs bekamen beide als Belohnung ein Stück Wurst, im zweiten Teil bekam nur einer der beiden Wurst, der andere ging leer aus. „Wir haben uns angesehen, wie oft das Subjekt die Pfote im Gleichheitszustand und im Ungleichheitszustand gegeben hat, und die Antworten verglichen, um festzustellen, in welchem Zustand die Hunde früher aufgegeben haben“, erklärt der Verhaltensforscher Jim McGetrick.
Im zweiten Teil der Studie durften die Hunde nach der Pfoten-Aufgabe gemeinsam aus einer Schüssel fressen. Im dritten und letzten Teil durften die Hunde in einem Raum mit ihren Herrchen oder Frauchen und der Person, die das Experiment durchgeführt hat, kuscheln. Die Idee hinter diesen beiden Aufgaben ist, dass sich Hunde in sozialen Situationen anders verhalten, wenn sie zuvor bei der Pfoten-Aufgabe ungerecht behandelt wurden. Hunde, die kein Leckerli bekommen haben, sollten also nicht so gerne ihr Futter teilen bzw. auf die Person, die das Experiment durchgeführt hat, zugehen.

Foto: Hilary Halliwell / Pexels.
Was ist Gerechtigkeit?
Insgesamt konnten die Forscher*innen keinen signifikanten Einfluss der Rasse auf das Verhalten der Hunde feststellen. Sowohl eher kooperative als auch unkooperative Hunderassen mögen Gerechtigkeit und reagieren negativ, wenn sie Ungerechtigkeit erfahren. Doch inwiefern kann man bei Tieren überhaupt davon sprechen, dass Gerechtigkeit und Ungerechtigkeit verstehen?
„Es ist wichtig, zu erkennen, dass wir nicht wissen, welche kognitiven Prozesse an den von uns beobachteten negativen Reaktionen auf Ungleichheit beteiligt sind“, erklärt der Forscher Jim McGetrick. „Insbesondere bei Hunden, die bei experimentellen Aufgaben eine sehr grundlegende negative Reaktion auf Ungerechitgkeit zeigen, ist es möglich, dass diesen Reaktionen sehr einfache Prozesse zugrunde liegen, so dass das Individuum kein explizites Bewusstsein für die Ungerechtigkeit hat und nur indirekt darauf reagiert.“
Man müsse hier auch zwischen Arten entscheiden, so der Forscher. Bei Hunden scheint der Gerechtigkeitssinn grundlegender zu sein als etwa bei Kapuzineraffen. Hunde geben nämlich weiterhin die Pfote, wenn sie eine schlechtere Belohnung als ein Kollege erhalten (etwa eine Karotte statt einer Wurst). Bei Kapuzineraffen ist es mit der Kooperation vorbei, sobald sie verstehen, dass ihr Kollege eine Traube bekommt, während sie selbst nur eine Gurke erhalten.

Foto: Britta Mang.